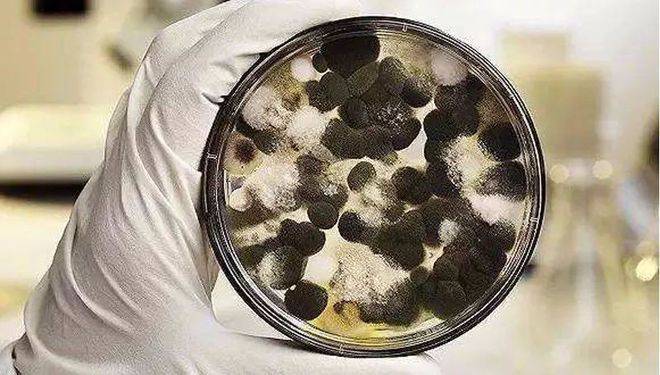
2.霉菌载玻片湿室培养.1.根霉假根的观察.实验内容

根霉培养基

霉菌液体培养基
图片尺寸480x168
米根霉 - 百度百科
图片尺寸725x654
显色培养基
图片尺寸806x662
根霉(面包霉菌)是一种常见的腐生真菌,根霉(面包霉菌)在显微镜下的
图片尺寸1200x800
根霉是显微镜下教育植物上常见的腐生真菌属.
图片尺寸1200x800
黑根霉植物软腐组织分离冻干粉马铃薯葡萄糖琼脂培养基28度活化
图片尺寸800x800
(根霉在pda培养基上)
图片尺寸585x430
中华根霉(菌种)
图片尺寸924x699
西葫芦根霉腐烂病危害特征
图片尺寸600x380
图1-46根霉的菌丝体.png
图片尺寸441x328
2.霉菌载玻片湿室培养.1.根霉假根的观察.实验内容
图片尺寸660x375
显微镜下的霉菌根霉水果上长出的黑色毛毛
图片尺寸1440x1920
一种新型米根霉菌株g1及其培养方法和应用-爱企查
图片尺寸415x226
黑根霉植物软腐组织分离冻干粉马铃薯葡萄糖琼脂培养基28度活化
图片尺寸800x800
根霉的形态和构造
图片尺寸1163x557
根霉属
图片尺寸220x165
根霉(面包霉)是一种常见的腐生真菌,显微镜下的根霉(面包霉).
图片尺寸1200x800
三,实验材料 根霉,赤霉,黑曲霉,青霉菌落平板 根霉,曲霉平板菌落
图片尺寸1080x810
米根霉的培养方法
图片尺寸524x458
真菌的特点(3) 无隔菌丝和有隔菌丝 无隔菌丝:根霉,毛霉 有隔菌丝
图片尺寸1080x810